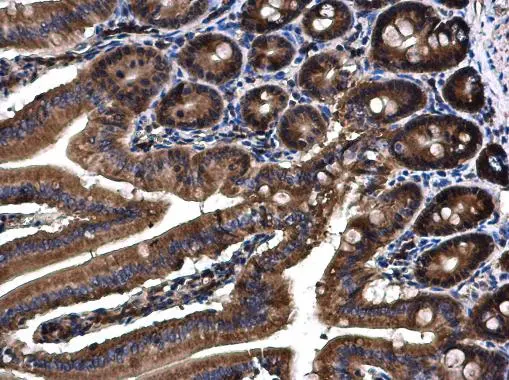
Angiopoietin 4 antibody detects Angiopoietin 4 protein at cytoplasm on mouse duodenum by immunohistochemical analysis. Sample: Paraffin-embedded mouse duodenum. Angiopoietin 4 antibody (GTX100993) diluted at 1:500.
Antigen Retrieval: Citrate buffer, pH 6.0, 15 min Angiopoietin 4 antibody detects Angiopoietin 4 protein at cytoplasm on mouse duodenum by immunohistochemical analysis. Sample: Paraffin-embedded mouse duodenum. Angiopoietin 4 antibody (GTX100993) diluted at 1:500.
Antigen Retrieval: Citrate buffer, pH 6.0, 15 min

Sample (30μg whole cell lysate) A:H1299 B:Hep G2 (GTX27900) C:MOLT4 (GTX27912) 7.5% SDS PAGE GTX100993 diluted at 1:500
Angiopoietin 4 antibody
GTX100993
ApplicationsWestern Blot, ImmunoHistoChemistry, ImmunoHistoChemistry Paraffin
Product group Antibodies
ReactivityHuman, Mouse
TargetANGPT4
Overview
- SupplierGeneTex
- Product NameAngiopoietin 4 antibody
- Delivery Days Customer9
- Application Supplier NoteWB: 1:500-1:3000. IHC-P: 1:100-1:1000. *Optimal dilutions/concentrations should be determined by the researcher.Not tested in other applications.
- ApplicationsWestern Blot, ImmunoHistoChemistry, ImmunoHistoChemistry Paraffin
- CertificationResearch Use Only
- ClonalityPolyclonal
- Concentration1 mg/ml
- ConjugateUnconjugated
- Gene ID51378
- Target nameANGPT4
- Target descriptionangiopoietin 4
- Target synonymsANG3, ANG4, angiopoietin-4
- HostRabbit
- IsotypeIgG
- Protein IDQ9Y264
- Protein NameAngiopoietin-4
- Scientific DescriptionAngiopoietins are proteins with important roles in vascular development and angiogenesis. All angiopoietins bind with similar affinity to an endothelial cell-specific tyrosine-protein kinase receptor. The mechanism by which they contribute to angiogenesis is thought to involve regulation of endothelial cell interactions with supporting perivascular cells. The protein encoded by this gene functions as an agonist and is an angiopoietin. [provided by RefSeq]
- ReactivityHuman, Mouse
- Storage Instruction-20°C or -80°C,2°C to 8°C
- UNSPSC41116161

![WB analysis of Jurkat cell lysate using GTX52541 Angiopoietin 4 antibody [11M11].](https://www.genetex.com/upload/website/prouct_img/normal/GTX52541/GTX52541_20191119_WB_w_23060900_139.webp)

